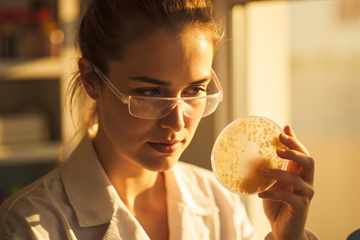

Are you aiming to improve your expertise in the food industry? Food analysis training programs offer a way to gain key knowledge and practical skills. These programs are designed to provide a comprehensive grasp of food composition, testing methodologies, and quality control processes. By enrolling in a food analysis training program, individuals can improve their career prospects and contribute to guaranteeing food safety and quality.
This article explores some of the top food analysis training programs available, highlighting their key features and benefits. Whether one is a seasoned professional or new to the field, this guide will assist in finding the perfect course to meet one's specific needs and boost professional development.
Top Food Analysis Training Programs: Improve Your Skills and Career
Key Takeaways
- Food analysis training is crucial for ensuring food safety, quality, and regulatory compliance in the food industry.
- Key skills gained from food analysis training include analytical techniques, microbiology, sensory evaluation, data analysis, and quality control.
- Choosing the right training program depends on individual career goals, current skill level, learning style, budget, and time commitment.
- Top food analysis training programs vary in course content, duration, delivery method, cost, and certification, catering to different needs and career paths.
- Career opportunities after completing food analysis training include roles such as food analyst, quality control specialist, food safety auditor, research scientist, and regulatory affairs specialist.
- Salary expectations in food analysis roles vary based on experience and location, with potential for career advancement and specialization.
- Investing in food analysis training provides long-term career benefits and enables individuals to excel in the food industry.
Table of Contents
- Top Food Analysis Training Programs: Improve Your Skills and Career
- Introduction: Why Food Analysis Training is Important
- Key Skills and Knowledge Gained from Food Analysis Training
- Top Food Analysis Training Programs: A Detailed Comparison
- Choosing the Right Food Analysis Training Program for Your Career Goals
- Career Opportunities After Completing Food Analysis Training
- Conclusion: Investing in Your Future with Food Analysis Training
- Frequently Asked Questions
Introduction: Why Food Analysis Training is Important
The food industry is placing increased emphasis on food analysis, making it more important than ever. Food analysis is how professionals ensure food products are safe, of good quality, and meet regulations. This article guides people in choosing the best food analysis training programs to improve their skills and career opportunities.
Food analysis training offers key benefits, including better job opportunities and deeper knowledge in the field. With proper training, individuals can contribute to producing safer, higher-quality food products. Continue reading to explore available food analysis training options and how they can help advance your career.
Key Skills and Knowledge Gained from Food Analysis Training
Food analysis training programs equip professionals with specific skills and knowledge. These skills are directly applicable to roles such as food scientists, quality assurance managers, and lab technicians. Training covers several key areas:
- Analytical Techniques: Individuals learn techniques like chromatography and spectroscopy, which are vital for identifying and quantifying food components.
- Microbiology: Training includes knowledge of microorganisms in food, which helps in preventing spoilage and promoting safety.
- Sensory Evaluation: Participants develop skills in evaluating food products based on taste, smell, and appearance.
- Data Analysis: Professionals learn to analyze data to make informed decisions about food quality and safety.
- Quality Control: Training focuses on quality control to maintain consistent standards in food production.
These skills gained from food analysis training contribute to better food products and safer practices. For example, a trained food scientist can use chromatography to detect contaminants, making sure only safe products reach consumers. Quality assurance managers apply their knowledge to maintain high standards, while lab technicians use analytical techniques to monitor food quality. The practical focus of the training ensures professionals are ready for real-world challenges in the food industry.
Analytical Techniques: Knowing the Tools of Food Analysis
Analytical techniques are a cornerstone of food analysis training. These techniques provide the means to examine food composition, identify contaminants, and ensure food products meet quality standards. Students gain hands-on experience with various instruments, making them proficient in:
- Chromatography (HPLC, GC): Used to separate and analyze complex mixtures. For example, High-Performance Liquid Chromatography (HPLC) can quantify vitamins in food, while Gas Chromatography (GC) identifies fatty acids.
- Spectroscopy (UV-Vis, IR): These methods measure how substances interact with light. UV-Vis spectroscopy can determine the color and clarity of liquids, and Infrared (IR) spectroscopy identifies organic compounds.
- Mass Spectrometry: Often coupled with chromatography, it identifies substances by their mass. This is crucial for detecting pesticide residues or identifying unknown contaminants.
In food analysis training, students use these techniques to analyze nutritional content, detect additives, and identify contaminants. For instance, they might use mass spectrometry to detect trace amounts of allergens. The practical experience gained directly contributes to the key skills needed for roles in food science and quality assurance.
Microbiology and Food Safety: Promoting Safe Food Production
Microbiology plays a crucial role in food analysis training, focusing on how to keep food safe. Training covers microbial growth, detecting pathogens like Salmonella and E. coli, and methods to control microbial contamination. Food analysts use microbiological techniques to check the safety and quality of food products.
- Microbial Growth: Knowing how microbes grow helps in predicting and preventing spoilage.
- Pathogen Detection: Identifying harmful bacteria makes sure that contaminated food does not reach consumers.
- Contamination Control: Learning methods to prevent contamination keeps food production safe.
Foodborne illnesses can be prevented through proper analysis. For instance, regular testing can detect Salmonella in poultry, preventing outbreaks. Food microbiology also involves regulatory compliance, making sure all food products meet required safety standards. This training provides key skills for maintaining food safety and quality in the industry.
Data Analysis and Quality Control: Interpreting Results and Maintaining Standards
Data analysis and quality control are vital in food analysis training. Food analysts use statistical methods to understand analytical data, which helps confirm the accuracy and reliability of results. Training includes:
- Quality Assurance: Learning how to plan and maintain quality in food production.
- Quality Control Charts: Using charts to monitor processes and detect deviations from standards.
- Method Validation: Verifying that analytical methods are accurate and reliable.
These skills are needed to maintain consistent product quality and meet regulatory requirements. Data analysis helps identify trends, spot unusual results, and make informed decisions. For example, analysts might use control charts to monitor the weight of packaged goods, helping them meet label claims. This focus on data and quality provides key skills for helping food products are safe and meet standards.
Top Food Analysis Training Programs: A Detailed Comparison

Selecting the right food analysis training program is important for career advancement. Here's a comparison of some top programs, considering course content, duration, delivery method, cost, and certification:
| Program | Course Content | Duration | Delivery Method | Cost | Certification | Strengths | Weaknesses | Target Audience |
|---|---|---|---|---|---|---|---|---|
| University A Food Science Program | Comprehensive food chemistry, microbiology, and analysis | 4 years (Bachelor's) | In-person | Varies by university | BSc Food Science | Extensive curriculum, research opportunities | Long duration, higher cost | Students seeking a broad academic background |
| College B Food Safety Course | Focus on food safety regulations, HACCP, and basic analysis | 1 year (Certificate) | In-person/Online | Moderate | Food Safety Certificate | Practical skills, shorter duration | Less in-depth than a degree program | Professionals needing specific food safety knowledge |
| Specialized Training Provider C Food Analysis Training | Hands-on training in chromatography, spectroscopy, and data analysis | 2 weeks (Intensive) | In-person | High | Food Analysis Certification | Intensive, hands-on experience with advanced techniques | Short duration may not cover all topics | Lab technicians and analysts seeking specialized skills |
These food analysis training programs vary in their approach, depth, and focus. The best choice depends on individual career goals and current skill level. Consider practical, hands-on experience when evaluating programs.
Choosing the Right Food Analysis Training Program for Your Career Goals
Selecting the right food analysis training program requires careful consideration of your career goals, current skills, and personal preferences. Here’s how to make an informed decision:
- Define Your Career Aspirations: Are you interested in research, quality control, or product development? Different programs cater to specific career paths.
- Assess Your Current Skill Level: Do you need a foundational course or advanced training in a specific technique?
- Consider Your Learning Style: Do you prefer hands-on, in-person training or the flexibility of online courses?
- Set a Budget: Food analysis training programs vary in cost. Determine what you can afford.
- Evaluate Time Commitment: Some programs are short and intensive, while others require a longer commitment.
When evaluating programs, consider accreditation, instructor qualifications, and industry recognition. A program aligned with your long-term career objectives will provide the best return on investment. Use the following checklist to assess your needs:
- What are my primary career goals in the food industry?
- What specific skills do I need to develop or improve?
- What is my preferred learning style (in-person, online, blended)?
- What is my budget for food analysis training?
- How much time can I commit to a training program?
Carefully consider these factors to make an informed choice about your food analysis training.
Assess Your Career Goals and Skill Level
Choosing the right food analysis training starts with knowing your career goals and current skills. Here’s a self-assessment process to help you identify your aspirations and skill level:
- Identify Your Career Aspirations:
- What specific area of the food industry interests you (e.g., research, quality assurance, product development)?
- What are your long-term career objectives? Do you want to lead a lab, develop new products, or make sure food is safe?
- Evaluate Your Current Skills:
- What skills and knowledge do you already have in food analysis?
- Are you familiar with analytical techniques like chromatography or microbiology?
- Do you have experience with data analysis and quality control?
- Consider Valuable Skills for Different Career Paths:
- Research: Requires strong analytical and problem-solving skills.
- Quality Assurance: Needs attention to detail and knowledge of regulations.
- Product Development: Demands creativity and a grasp of food chemistry.
for example, if you want to work in quality assurance, focus on programs that offer training in quality control, HACCP, and regulatory compliance. Knowing your goals and skill level is crucial for choosing a training program that fits with your needs and helps you achieve your career objectives.
Key Factors When Evaluating Training Programs
When evaluating food analysis training programs, consider these key factors to make sure the program fits your needs:
- Course Content:
- Does the program cover the specific analytical techniques you need (e.g., chromatography, spectroscopy, microbiology)?
- Does it include relevant topics like food safety, quality control, and regulatory compliance?
- Curriculum Structure:
- Is the curriculum well-organized and easy to follow?
- Does it offer a mix of theoretical knowledge and practical, hands-on experience?
- Duration and Delivery Method:
- How long is the program, and does it fit your schedule?
- Is it offered online, in-person, or in a blended format?
- Cost and Payment Options:
- What is the total cost of the program, including tuition, materials, and any additional fees?
- Are there flexible payment plans or financial aid options available?
- Accreditation and Industry Recognition:
- Is the program accredited by a reputable organization?
- Is it recognized by employers in the food industry?
- Instructor Qualifications:
- What are the qualifications and experience of the instructors?
- Are they experts in their respective fields?
Align the program’s focus with your career goals. A program that meets these criteria will provide valuable training and increase your career prospects.
Checklist: Finding the Perfect Fit
Use this checklist to evaluate potential food analysis training programs and find the one that best fits your needs. Answer each question and assign a score from 1 (not important) to 5 (very important).
- Career Goals:
- Does the program align with my long-term career objectives? (1-5)
- Does it offer training in the specific area of food analysis I'm interested in? (1-5)
- Skill Level:
- Does the program match my current skill level and knowledge? (1-5)
- Does it offer foundational courses if needed? (1-5)
- Program Content:
- Does the program cover the analytical techniques I need to learn? (1-5)
- Does it include relevant topics like food safety, quality control, and regulatory compliance? (1-5)
- Delivery Method:
- Does the delivery method (online, in-person, blended) fit my learning style and schedule? (1-5)
- Cost:
- Is the program affordable and within my budget? (1-5)
- Accreditation:
- Is the program accredited by a reputable organization? (1-5)
- Instructor Qualifications:
- Are the instructors experts in their respective fields? (1-5)
Scoring: Add up your scores for each program. The program with the highest score is likely the best fit for you.
Visit program websites, attend information sessions, and speak with current students or alumni. Take this checklist and start your search for the perfect training program today!
Career Opportunities After Completing Food Analysis Training
Completing food analysis training opens doors to various career opportunities in the food industry. The growing demand for skilled professionals, driven by increasing consumer awareness and stricter regulations, makes this a promising field.
- Food Analyst: Conducts tests on food products to ensure they meet quality and safety standards.
- Quality Control Specialist: Monitors production processes and implements quality control procedures.
- Food Safety Auditor: Inspects food processing facilities to ensure compliance with safety regulations.
- Research Scientist: Conducts research to improve food products and develop new analytical methods.
- Regulatory Affairs Specialist: Ensures that food products comply with government regulations and labeling requirements.
Salary expectations vary depending on the job role, experience, and location. However, professionals with food analysis training can expect competitive salaries and opportunities for career advancement. Job market trends indicate a steady increase in demand for these roles.
Companies that hire professionals with food analysis training include food manufacturers, testing laboratories, government agencies, and research institutions. Food analysis training is a key factor in career advancement, providing the skills and knowledge needed to succeed in these roles.
Job Roles and Responsibilities: A Detailed Overview
Food analysis training prepares individuals for a range of job roles in the food industry. Here’s a detailed look at some of these roles:
- Food Analyst:
- Responsibilities: Conducts chemical and microbiological tests on food samples, analyzes data, and writes reports.
- Day-to-Day Tasks: Preparing samples, operating lab equipment, interpreting results, and documenting findings.
- Required Skills: Strong analytical skills, knowledge of lab techniques, and attention to detail.
- Work Environment: Typically works in a laboratory setting.
- Example: Testing for contaminants in baby food to make sure it meets safety standards.
- Quality Control Specialist:
- Responsibilities: Monitors production processes, implements quality control procedures, and makes sure products meet standards.
- Day-to-Day Tasks: Inspecting production lines, collecting samples, analyzing data, and recommending improvements.
- Required Skills: Knowledge of quality control principles, attention to detail, and problem-solving abilities.
- Work Environment: Works in food processing plants or manufacturing facilities.
- Example: Regularly checking the pH levels of yogurt during production to maintain consistency.
- Food Safety Auditor:
- Responsibilities: Inspects food processing facilities to confirm compliance with safety regulations and standards.
- Day-to-Day Tasks: Conducting audits, reviewing documentation, and providing recommendations for improvement.
- Required Skills: Knowledge of food safety regulations, auditing skills, and communication abilities.
- Work Environment: Travels to different food processing facilities.
- Example: Inspecting a meat processing plant to confirm it follows HACCP guidelines.
- Research Scientist:
- Responsibilities: Conducts research to improve food products, develop new analytical methods, and study food-related issues.
- Day-to-Day Tasks: Designing experiments, collecting data, analyzing results, and writing research papers.
- Required Skills: Strong research skills, knowledge of food science, and analytical abilities.
- Work Environment: Works in research labs or academic institutions.
- Example: Developing a new method to detect allergens in food more efficiently.
- Regulatory Affairs Specialist:
- Responsibilities: Makes sure that food products comply with government regulations and labeling requirements.
- Day-to-Day Tasks: Reviewing regulations, preparing documentation, and communicating with regulatory agencies.
- Required Skills: Knowledge of food regulations, attention to detail, and communication skills.
- Work Environment: Works in food companies or regulatory agencies.
- Example: Making sure that a new food product’s label meets all legal requirements.
Food analysis training is key for preparing individuals for these roles, providing the necessary skills and knowledge to succeed.
Salary Expectations and Job Market Trends
Salary expectations for food analysis roles vary based on experience, education, and location. Here’s an overview of what you can expect:
- Food Analyst: Entry-level positions typically range from $45,000 to $60,000 annually. With experience, salaries can reach $75,000 or more.
- Quality Control Specialist: Salaries generally range from $50,000 to $70,000 annually, with potential for higher earnings with experience.
- Food Safety Auditor: Average salaries range from $60,000 to $80,000 annually, depending on experience and certifications.
- Research Scientist: Salaries can range from $65,000 to $90,000 or more, depending on education and research experience.
- Regulatory Affairs Specialist: Average salaries range from $70,000 to $95,000 annually, with potential for higher earnings in senior roles.
Job market trends indicate a growing demand for skilled food analysts. According to a report by the Bureau of Labor Statistics, employment in the food science field is projected to grow by 7% over the next decade. Areas experiencing the most growth include food safety, quality assurance, and regulatory compliance.
Food analysis training increases earning potential by providing the skills and knowledge needed to excel in these roles. Professionals with specialized training and certifications are often in higher demand and command higher salaries.
Career Advancement and Specialization Opportunities
Food analysis training provides a solid foundation for career advancement and specialization in the food industry. Here are potential career paths and opportunities:
- Specialization Areas:
- Microbiology: Focus on detecting and controlling harmful microorganisms in food.
- Chemistry: Specialize in analyzing the chemical composition of food and identifying contaminants.
- Sensory Evaluation: Develop expertise in evaluating food products based on taste, smell, and appearance.
- Food Safety: Concentrate on food safety regulations, auditing, and compliance.
- Further Education and Certifications:
- Obtain advanced degrees (Master's, PhD) to improve research and analytical skills.
- Pursue certifications in food safety (e.g., HACCP), quality control, and auditing.
- Career Advancement Paths:
- Move from entry-level positions (e.g., Food Analyst) to supervisory or management roles (e.g., Lab Manager, Quality Assurance Manager).
- Advance to specialized positions (e.g., Senior Research Scientist, Regulatory Affairs Director).
Successful professionals have advanced their careers through food analysis training and specialization. For example, a food analyst who specializes in microbiology might become a lead microbiologist, overseeing all microbiological testing in a food processing plant. Investing in food analysis training offers long-term career benefits, providing the skills and knowledge needed to achieve career goals.
Conclusion: Investing in Your Future with Food Analysis Training
Food analysis training offers many benefits, and it is important for career advancement in the food industry. The skills and knowledge gained through training are valuable for promoting food safety, quality, and regulatory compliance. By enrolling in a suitable training program, individuals can take the next step in their professional development.
Explore the recommended programs and invest in your future. Food analysis training provides opportunities and enables individuals to excel in this field.
Frequently Asked Questions
- What qualifications or prerequisites are typically required for enrolling in food analysis training programs?
- Most food analysis training programs require a foundational understanding of food science or a related field. Applicants often need a high school diploma or equivalent, while some advanced programs may require a bachelor’s degree in food science, chemistry, biology, or a related discipline. Additionally, prior laboratory experience or coursework in analytical techniques can be beneficial.
- How can I determine which food analysis training program is best suited for my career goals?
- To find the right food analysis training program, consider factors such as your current skill level, career objectives, and the specific areas of food analysis that interest you (e.g., microbiology, chemical analysis, sensory evaluation). Research the curriculum, faculty expertise, and any industry partnerships the program may have. Additionally, seeking reviews from former students and exploring job placement rates can provide valuable insights.
- Are there online options available for food analysis training programs, and how do they compare to in-person classes?
- Yes, many institutions offer online food analysis training programs, which provide flexibility for working professionals. Online courses can be just as rigorous as in-person classes, often featuring interactive modules, virtual labs, and live discussions. However, in-person classes may offer more hands-on experience and direct access to laboratory equipment. Consider your learning style and schedule when deciding between online and in-person options.
- What career opportunities can I pursue after completing a food analysis training program?
- Graduates of food analysis training programs can pursue various careers in the food industry, including roles as food scientists, quality assurance analysts, regulatory affairs specialists, or laboratory technicians. Opportunities also exist in government agencies, research institutions, and food manufacturing companies. Additionally, further specialization or certifications can enhance job prospects and advancement opportunities.
- How often do food analysis training programs update their curriculum to reflect industry changes?
- Reputable food analysis training programs regularly review and update their curricula to align with advancements in food science and technology, regulatory requirements, and industry trends. Many programs collaborate with industry professionals to ensure that course content remains relevant and incorporates new analytical techniques and tools. It is advisable to inquire about the program’s curriculum review process when considering enrollment.